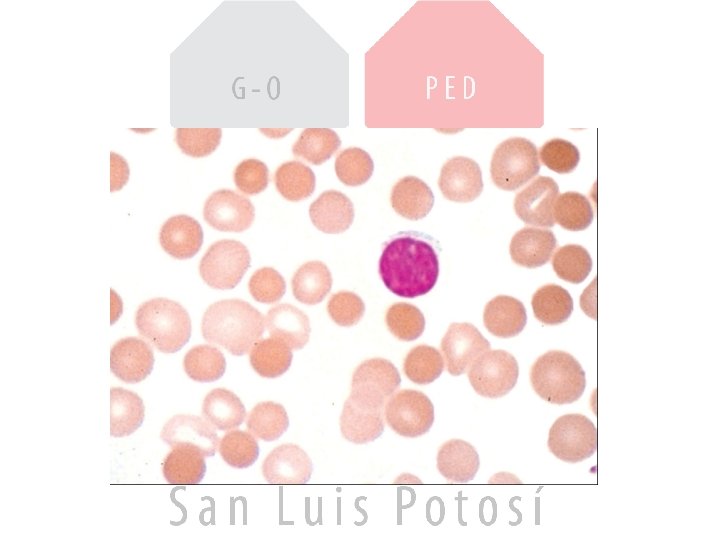

EL NIO CON ANEMIA Causas y tratamiento ANEMIA

















































































- Slides: 81

EL NIÑO CON ANEMIA Causas y tratamiento

ANEMIA • Es la reducción en la cifra de hemoglobina por unidad de volumen, tomando en cuenta edad, género, altura sobre el nivel del mar. • La OMS considera anemia con Hb <13 gr en hombres y 12 gr/L en mujeres • < 11 grs en embarazo • En niños de acuerdo a su edad y género

ANEXO 1: VALORES NORMALES DE LA BIOMETRÍA HEMÁTICA DE ACUERDO A EDAD Edad Hb(g%) Hematocrito(%) MCV (f. L) MCHC (g/% RBC) Reticulocitos Leucocitos Plaquetas Recién nacido 18. 5(14. 5) 56(45) 108(95) 33(29) 1. 8 -4. 6 9400 -34000 192000 1 mes 13. 9(10. 7) 44(33) 101(91) 31. 8(28. 1) 0. 1 -0. 7 4000 -19500 252000 6 meses 12. 6(11. 1) 36(31) 76(68) 35(32. 7) 0. 7 -2. 3 6000 -17500 252000 12(10. 5) 36(33) 78(70) 33(30) 0. 7 -2. 3 6000 -17000 150000 -350000 2 -6 años 12. 5(11. 5) 37(34) 81(75) 34(31) 0. 5 -1. 0 5000 -15500 150000 -350000 6 -12 años 13. 5(11. 5) 40(35) 86(77) 34(31) 0. 5 -1. 0 4500 -13500 150000 -350000 12 -18 años Masculino 14. 5(13) 43(36) 88(78) 34(31) 0. 5 -1. 0 4500 -13500 150000 -350000 12 -18 años femenino 14(12) 41(37) 90(78) 34(31) 0. 5 -1. 0 4500 -13500 150000 -350000 Adulto masculino 15. 5(13. 5) 47(41) 90(80) 34(31) 0. 8 -2. 5 4500 -11000 150000 -350000 Adulto femenino 14(12) 41(36) 90(80) 34(31) 0. 8 -4. 1 4500 -11000 150000 -350000 6 meses a 2 años Notas: a El dato entre paréntesis se refiere a -2 desviaciones estándar b Algunos autores consideran 450000 plaquetas/ml el límite máximo Datos obtenidos de “The Johns Hopkins Hospital, The Harriet Lane Handbook”, Editorial Mosby, 15ª edición, 2000, págs: 324, 325.

ANEMIA • El defecto fisiológico es la disminución en la capacidad de transportar oxigeno en la sangre y una disminución en el oxigeno disponible en los tejidos. • Existen mecanismos humorales que regulan los cambios en la relación entre el requerimiento de oxigeno por los tejidos y la eritropoyesis.

Anemia • Es un problema de salud pública que afecta a todos los grupos etáreos con severas consecuencias para la salud y para el desarrollo social y económico • Las mujeres embarazadas y los niños pequeños son los grupos de mayor riesgo • El 50% de los casos de anemia es debida a deficiencia de hierro.

ANEMIA • La anemia es un SINDROME de múltiples etiologías • Constituye la mayor categoría de problemas hematológicos de la infancia y la adolescencia

CLASIFICACION

Sobre una base etiológica – Aumento en la perdida o destrucción de los eritrocitos. • Hemorragia aguda o crónica • Hemólisis congénita o adquirida – Disminución en la producción • • • Deficiencia de substancias para síntesis de Hb Depresión o inhibición de la MO Interferencia mecánica o infiltración de la MO Secundaria a enfermedades sistémicas Diseritropoyesis

Reticulocito • Glóbulo rojo “joven” con restos de material nuclear – Alto: Anemia regenerativa • Hemólisis • Perdida de sangre – Bajo: Anemia arregenerativa • Alteración en la producción de GR. • La cuenta deberá ajustarse al nivel de anemia para obtener el indice: valor de reticulocitos reportado x (Hto paciente/ Hto normal)

Reticulocitos

Basada en la Morfología • Se basa en: • Los valores del volumen corpuscular medio del eritrocito (VCM) y • La concentración de la hemoglobina corpuscular media (CMHG)

EDAD Hemoglobina VCM Recién Nacido 1 semana 2 meses 6 meses 1 año 14 años 18. 5 (14. 5) 16. 6 (13. 4) 11. 2 (9. 4) 12. 6 (11. 1) 12 (11. 5) 14. 5 (12) 113 ± 0. 8 fl 106 ± 6 fl 95 fl 78 ± 0. 7 fl 73 ± 1. 1 fl 81 ± 1. 1 fl Guest-Brown. Am J Dis Child 1957: 94; 486

ANEXO 1: VALORES NORMALES DE LA BIOMETRÍA HEMÁTICA DE ACUERDO A EDAD Edad Hb(g%) Hematocrito(%) MCV (f. L) MCHC (g/% RBC) Reticulocitos Leucocitos Plaquetas Recién nacido 18. 5(14. 5) 56(45) 108(95) 33(29) 1. 8 -4. 6 9400 -34000 192000 1 mes 13. 9(10. 7) 44(33) 101(91) 31. 8(28. 1) 0. 1 -0. 7 4000 -19500 252000 6 meses 12. 6(11. 1) 36(31) 76(68) 35(32. 7) 0. 7 -2. 3 6000 -17500 252000 12(10. 5) 36(33) 78(70) 33(30) 0. 7 -2. 3 6000 -17000 150000 -350000 2 -6 años 12. 5(11. 5) 37(34) 81(75) 34(31) 0. 5 -1. 0 5000 -15500 150000 -350000 6 -12 años 13. 5(11. 5) 40(35) 86(77) 34(31) 0. 5 -1. 0 4500 -13500 150000 -350000 12 -18 años Masculino 14. 5(13) 43(36) 88(78) 34(31) 0. 5 -1. 0 4500 -13500 150000 -350000 12 -18 años femenino 14(12) 41(37) 90(78) 34(31) 0. 5 -1. 0 4500 -13500 150000 -350000 Adulto masculino 15. 5(13. 5) 47(41) 90(80) 34(31) 0. 8 -2. 5 4500 -11000 150000 -350000 Adulto femenino 14(12) 41(36) 90(80) 34(31) 0. 8 -4. 1 4500 -11000 150000 -350000 6 meses a 2 años Notas: a El dato entre paréntesis se refiere a -2 desviaciones estándar b Algunos autores consideran 450000 plaquetas/ml el límite máximo Datos obtenidos de “The Johns Hopkins Hospital, The Harriet Lane Handbook”, Editorial Mosby, 15ª edición, 2000, págs: 324, 325.

• VCM nos informa del tamaño del glóbulo rojo. – Normocítica – Microcítica – Macrocítica • CMHG – Normal-Normocrómico – Disminuido-hipocrómico – Aumentado-hipercrómico

Clasificación Morfológica • Anemia Normocítica Normocrómica (VCM 80100 fl, CMHG 32 -36 g/dl) • Anemia Microcítica Normocrómica (VCM 6080 fl, CMHG 32 -36 g/dl). • Anemia Microcítica Hipocrómica (VCM 60 -80 fl, CMHG 20 -30 g/dl). • Anemia Macrocítica Normocrómica (VCM 101160 fl, CMHG 32 -36 g/dl).

Anemia Regenerativa • Anemia hemolítica • Anemia Perdida aguda de sangre



ANEMIA HEMOLITICA CORPUSCULARES: I. Defecto de membrana. A. Defecto primario con alteraciones morfológicas especificas. B. Defecto secundario: Abetalipoproteinemia. II. Defectos Enzimáticos. III. Defectos de la hemoglobina. IV. Anemias congénitas diseritropoyeticas. EXTRACORPUSCULARES I. Inmune A. Isoinmune. Enfermedad hemolítica del RN. Transfusión de sangre incompatible. B. Autoinmune. II. No inmune.

Anemias hemolíticas corpusculares por defecto de membrana • • Esferocitosis hereditaria Eliptocitosis Estomatocitosis Acantocitosis Xerocitosis Piropoiquilocitosis Se diagnostican con base en la revisión del frotis de sangre por sus características morfológicas.

ESFEROCITOSIS HEREDITARIA • Herencia autosómica dominante (75%) y recesiva • No hay historia familiar en el 25% de los casos. • Algunos tienen alteraciones de laboratorio leves, lo que sugiere un estado de portador (recesivo). • Puede ser una mutación de novo. • El defecto estructural primario es la inestabilidad de la membrana por deficiencia o disfunción de una proteína(espectrina) del esqueleto del eritrocito o las proteinas que anclan la espectrina a la membrana (ankirina, proteina 4. 2, banda 3)


ESFEROCITOSIS HEREDITARIA CARACTERÍSTICAS CLÍNICAS • Anemia e ictericia: dependen del grado de hemólisis, el grado de compensación de anemia (reticulocitosis), habilidad del hígado para conjugar y excretar la BI. • Esplenomegalia. • Se presenta desde la etapa del RN. En la mayoría de los casos se diagnostica antes de la pubertad. • < 5% autosómica recesiva

Clasificación y Tratamiento Clasificación Portador Leve Moderada Severa Hb (g/dl) Nl 11 -15 8 -12 6 -8 Reticulocitos % <3 3. 1 -6 >6 >10 Bilirrubina (mg/dl) <1. 0 1 -2 >2 >3 Sangre fresca Nl Nl-aum aumentada Sangre incubada Leve aumentada Esplenectomia No neces No nece en la infancia Neces edad escolar Neces no <3 a Fragilidad Osmotica

CASO CLINICO EZS Masculino. 2 años de edad. Abuela materna con DM tipo 2, abuelo paterno esplenectomizado, padre esplenectomizado a los 19 años de edad. Una tia paterna con colelitiasis a los 10 años de edad. Madre y un hermano sanos. • Producto del II embarazo de termino, amenaza de aborto, resuelto por cesárea por DCP, Peso al nacer 3350 grs. , no hipoxia perinatal. Hiperbilirrubinemia indirecta al 5º día de vida, manejada con fototerapia. • PA inició al 4 mes de edad con palidez progresiva, recibió transfusión de paquete globular al 4 y 5 mes de vida. Ha cursado con ictericia conjuntival y coluria que aumenta y disminuye. Episodios de dolor abdominal tipo cólico, intenso en epigastrio y CSD • • • EF: ictericia conjuntival +, soplo sistólico en mesocardio, suave. Abdomen blando, depresible, dolor a la palpación profunda en hipocondrio derecho. Se palpa bazo a nivel de la cicatriz umbilical. • Laboratorio: BH: Hb 9. 0 grs, Hto 27%, VCM 70 fl, MCHC 36 g/dl, RDW 24. 1%, WBC 7700 K/u. L, Plaquetas 296 mil. Reticulocitos 9%. Grupo y Rh: A positivo. • Frotis de SP: se observan abundantes eritrocitos pequeños, esféricos, hipercrómicos. • Coombs directo negativo. • Bilirrubina total 2. 92 mg/dl. , BI 2. 4 mg/dl, TGO 70 U, TGP 40 U, DHL 750 U. • Ultrasonido abdominal con hígado normal, presencia de litos en vesícula biliar. Esplenomegalia.

CAUSAS DE ANEMIA HEMOLITICA CORPUSCULARES: 1. Defecto de membrana. 2. Defectos de la hemoglobina 3. Defectos Enzimáticos. EXTRACORPUSCULARES I. Inmune A. Isoinmune. Enfermedad hemolítica del RN. Transfusión de sangre incompatible. B. Autoinmune. II. No inmune.

ANEMIA HEMOLITICA DEFECTOS DE HEMOGLOBINA • CUALITATIVAS: Hemoglobinopatias: Hb S, C, H, M. • CUANTITATIVAS: Talasemias alfa y beta GRUPO HEM: • Porfiria eritropoyética congénita.

CAUSAS DE ANEMIA HEMOLITICA CORPUSCULARES: 1. Defecto de membrana. 2. Defectos de la hemoglobina 3. Defectos Enzimáticos. EXTRACORPUSCULARES I. Inmune A. Isoinmune. Enfermedad hemolítica del RN. Transfusión de sangre incompatible. B. Autoinmune. II. No inmune.

ANEMIA HEMOLITICA DEFECTOS ENZIMATICOS • También llamados anemias hemolíticas no esferocíticas. • Son extremadamente raros, exceptuando la (favismo) deficiencia de glucosa 6 fosfato deshidrogenasa y de piruvato quinasa. • La morfología del eritrocito es normal, con reticulocitosis y basofilia difusa al observar el frotis de sangre periferica. • La deficiencia de G 6 FD es el defecto genético mas común que afecta a millones de individuos en áreas subtropicales, confiere protección contra la malaria.

ANEMIA HEMOLITICA DEFECTOS ENZIMATICOS DEFECTOS DE ENERGIA: Via de Embden Meyerhof: anaeróbica, Defectos en la vía productora de ATP. • Glucosa fosfato isomerasa. • Hexoquinasa. • Fosfofructoquinasa. • Fosfoglicerato quinasa. • 2, 3 difosfogliceromutasa (policitemia sin hemolisis). • Piruvato kinasa. DEFECTOS DEL POTENCIAL REDUCTOR: Monofosfato Hexosa: aeróbica, deficiencias en la vía productora de NADPH. • Glucosa 6 Fosfato Deshidrogenasa. • • • 6 -Fosfogluconato dehidrogenasa Glutation reductasa Glutation sintetasa

CAUSAS DE ANEMIA HEMOLITICA CORPUSCULARES: 1. Defecto de membrana. 2. Defectos de la hemoglobina 3. Defectos Enzimáticos. EXTRACORPUSCULARES I. Inmune A. Isoinmune. Enfermedad hemolítica del RN. Transfusión de sangre incompatible. B. Autoinmune. II. No inmune. a) b) c) d) CID Quemaduras PTT, SUH, HPN Mecanicas

Anemia Hemolítica Autoinmune • DGM, masculino de 11 años de edad, originario de Tancanhuitz de Santos, S. L. P. • Antecedentes no relevantes para el cuadro actual. • Inició hace una semana con fiebre, dolor abdominal, vómito, irritabilidad y ataque al estado general. • Acudió a Hospital General de Valles, donde lo encuentran pálido, con ictericia, febril, y bazo palpable.

• En Cd Valles una BH mostró Hb 7. 5 grs, VCM 100 fl, CMHG 33, leucocitos 22 000, NT 7500, plaquetas 340 000/mm 3. células inmaduras en el frotis de SP. • BH a su llegada a urgencias con Hb 4. 5 gr, VCM 115 fl, CMHC 32, plaquetas 280 000/mm 3. Reticulocitos 15%. FSP con presencia de normoblastos (eritroblastos). • Bilirrubina indirecta 5 mgs. DHL 2000 U. • Coombs directo positivo 1: 320

• • Tratamiento: Reposo absoluto Oxigeno por puntas nasales Fowler Gamaglobulina IV 400 mgs/kg/dia Metilprednisolona 30 mgs/kg/dia Prednisona 2 mg/kg/dia Acido folico

Por grupos de edad • • Anemia del prematuro Anemia en el recién nacido Anemia en el niño menor de 2 años Anemia en el niño mayor de 2 años

Anemia del Prematuro • El hierro se deposita en el feto en el tercer trimestre del embarazo • El prematuro es un grupo de alto riesgo para deficiencia de hierro, nace con reservas bajas y las agota rápidamente • El RN presenta reducción del numero de GR durante las primeras semanas de vida • Disminución paulatina y constante de Hb, Hto y reticulocitos a partir de la segunda semana de VEU en el niño nacido pre termino (<1000 g) • Normocítica, normocrómica, hiporegenerativa

Anemia del prematuro causas • Falta de producción de eritropoyetina en respuesta a la hipoxia tisular. • Perdidas por flebotomía • Se recomienda monitorear al RN pre término mediante técnicas no invasivas (oximetría de pulso y captometria)y que muestras sanguíneas se procesen con micro técnica • La anemia en el prematuro tiene serias consecuencias agudas y a largo plazo sobre el desarrollo neurológico.

• La reducción en la cifra de Hb en las primeras semanas representa una adaptación fisiológica al ambiente extrauterino • En el prematuro esa reducción es mas prolongada y mas severa que en los de término. • El 90% de los pre término reciben transfusiones especialmente los < 1000 gr

Anemia del Prematuro Tratamiento • Transfusión de concentrado eritrocitarios • Eritropoyetina • Hierro

Anemia del Prematuro Transfusion de concentrado eritrocitario • Hematocrito < 20 % asociado a: – Paciente asintomatico con retis < 1% – Paciente con datos clinicos de hipoxia • Hto entre 21 y 30% asociado a: – Fraccion inspirada de oxigeno < 35% – CPAP o ventilacion mecanica con presion media de via aerea <6 cms H 2 O – Apnea o bradicardia: > de 6 en 6 hrs o mas de 2 en 24 hrs que requieran asistencia con mascarilla – FC >180/min o FR >80/min en 24 hs – Aumento peso <10 gr/dia con 100 kcal/kg/d después de 4 dias

Anemia del Prematuro Transfusión de concentrado eritrocitario • Hto entre 31 y 35% en niños con: – Fracción inspirada de oxigeno > 35% – CPAP o ventilación mecánica con presión media de la vía aérea > 6 cms H 2 O • Hto entre 36 – 45% en niños con: – Oxigenación con membrana extracorpórea – Cardiopatía congénita cianógena

Anemia del Prematuro Transfusión de concentrado eritrocitario • Casos especiales: – RN menor de 24 hrs de vida y hto < 40% – RN que será sometido a cirugía mayor para mantener Hto > 30% y Hb > 10 gr. – Pérdida aguda de sangre > 10% del volumen sanguíneo total. • Volumen recomendado de GR es 15 ± 5 ml/kg en 2 -4 hrs • En inestabilidad hemodinámica uso de furosemide 0. 5 – 1 mg/kg

Anemia del Prematuro Uso de eritropoyetina • RN pre término con peso al nacer < 1000 gr • RN pre término con peso al nacer entre 1000 gr a 1250 grs con: – Necesidad de asistencia ventilatoria durante > 48 hrs y Hto al nacer < 46% – Necesidad de asistencia ventilatoria durante > 48 hrs y extracción sanguínea de > 9 ml en las primeras 48 hrs – Necesidad de transfusión en las primeras 48 hrs de vida

Anemia del Prematuro Uso de eritropoyetina • Solo se deberá administrar si se puede ofrecer hierro oral • Antecedente de que el paciente ya recibió por lo menos una transfusión de PG • Si no tolera la via oral o no ha recibido transfusiones la eritropoyetina se indicara hasta que esto ocurra.

Prevención • Ofrecer terapia preventiva con hierro oral a la mujer gestante • Dosis recomendada de hierro elemental es de 60 mg al día a partir del segundo trimestre del embarazo y continuar administrando a la madre hasta 3 meses post parto • Niños pre termino o de bajo peso al nacer requieren suplementos con fármacos a razón de 2 -4 mgs/kg/día de Fe elemental desde el mes de edad hasta los 12 meses.

Anemia Arregenerativa • Microcitica Hipocrómica: Deficiencia de Hierro • Macrocítica Normocrómica: Deficiencia de folatos y Vit B 12, Hemólisis, Insuficiencia medular • Normocitica Normocrómica: – Neoplasias. Leucemia aguda – Insuficiencia renal – Hipotiroidismo – Enfermedad inflamatoria crónica

Deficiencia de Hierro • Es la deficiencia nutricional mas frecuente en la infancia y adolescencia • El 40 -50% de niños menores de 5 años en países en vías de desarrollo • Incidencia: 5. 5% en niños entre 5 -8 años, 2. 6% en niños pre adolescentes, 25% en adolescentes embarazadas • La incidencia es inversamente proporcional al estatus socio económico

• Dos picos de prevalencia: Lactantes y adolescentes • Períodos de rápido crecimiento con depleción de reservas de hierro • Bajos niveles de hierro en la dieta • Enteropatía exudativa debido a la ingesta excesiva de leche entera fresca de vaca • En el adolescente por rápido crecimiento, baja ingesta en dieta e inicio menstruación

Síntomas y signos de deficiencia de Fe • • Disminución capacidad física Parestesias Ardor en la lengua, disfagia, pica Glositis, estomatitis, queilitis angular Coiloniquia Esplenomegalia leve Desaceleración de crecimiento Déficit de atención, fracasos escolares

Deficiencia hierro < 2 años • El hierro es esencial para la neurogénesis y diferenciación apropiada de ciertas células y regiones cerebrales in útero y en la vida post natal. • En el primer año de vida ocurre rápido desarrollo neuronal • Causa cambios morfológicos, bioquímicos y bioenergéticos del SNC • Secuelas cognitivas a largo plazo

Anemia Microcitica Hipocromica

Requerimientos normales • El niño normal requiere 1 mg/kg/d máximo 15 mg/d, asumiendo que se absorbe el 10%. • El niño de bajo peso al nacer, con bajo nivel de Hb al nacer, pre termino requieren 2 mg/kg/dia maximo 15 mg/d

Deficiencia de hierro • El pinzar el cordón umbilical después de 30 a 180 segundos de haber salido los hombros por el canal del parto aporta hasta 75 mgs de hierro elemental al RN de termino, lo que le previene desarrollar deficiencia de hierro en los siguientes 6 meses. No así en el prematuro o en el RN de bajo peso al nacer

Reservas de hierro • El RN tiene 75 mg/kg de hierro corporal • Utiliza 35 -45 mg por cada Kg que aumenta • Si no obtiene Fe de la dieta consume sus reservas a los 6 m • El prematuro las consume a los 3 -4 m • La causa mas común de la deficiencia a esta edad es la ingesta insuficiente

• El menor de 2 años de edad tiene mayor riesgo para desarrollar deficiencia de hierro. • Es recomendable la suplementación con fármacos y alimentos de forma preventiva en este grupo de edad. • La educación a la familia se debe enfocar a conocer los alimentos que realzan la absorción y la utilización del hierro.



Fe Profiláctico de 6 -12 m • Niños con madre deficiente Fe en el embarazo. • Productos de embarazo múltiple • De termino Alimentados con leche entera de vaca • De termino alimentados exclusivamente con leche materna después del 6 to mes • Mala absorción o perdida crónica de Fe • Hemorragia neonatal

Fe profiláctico • Dosis de Fe profiláctico en el niño de 6 m a 1 año • 2 mg/kg/dia de hierro elemental • Sulfato ferroso gotas 25 mgs hierro elemental en 20 gotas • Fumarato ferroso 9. 6 mg de hierro elemental por ml • Fumarato ferroso tabletas 60 mgs fe elemental

Previniendo la deficiencia • Indicar lactancia materna y mantenerla por lo menos por 6 meses • Recomendar la ablactación con alimentos fortificados con hierro • La prevención de la deficiencia de hierro se debe llevar a cabo mediante las modificaciones a la dieta

• Fomentar la alimentación exclusiva con leche materna o en su defecto formulas infantiles fortificadas con hierro los primeros 4 -6 meses de vida. • Introducir alimentos ricos en hierro a partir de los 6 meses que aporten 1 mg/kg/día de hierro elemental, con alimentos ricos en vitamina C y continuar leche materna hasta el año de edad.

• Continuar con formulas de leche fortificada con hierro hasta los 12 meses de edad, para los que no reciben leche materna (de continuación). • Niños pre termino o de bajo peso al nacer requieren suplementos con fármacos a razón de 2 -4 mgs/kg/dia de Fe elemental desde el mes de edad hasta los 12 meses. • En niños de 1 -5 años limitar el consumo de leche de vaca o soya a no mas de 24 onzas/día y otros lácteos.

Fe en niños pretermito prevención • Comité de nutrición AAP – Alimentados con leche materna 2 mg/kg/dia – Alimentados con formulas 1 mg/kg/dia – Iniciar al mes de edad hasta los 12 meses • Por peso al nacimiento: Soc Pediátrica de Canadá – <1000 gr de 3 -4 mg/kg/dia. – >1000 gr 2 -3 mg/kg/día – Iniciando a las 6 -8 semanas hasta los 12 meses de edad corregida

• El RN es alimentado exclusivamente con leche hasta los 4 -6 m de vida. • Las formulas a base de leche de vaca y la leche materna contienen <1. 5 mg/1000 cal (0. 5 – 1. 5 mg/L) • Las formulas maternizadas fortificadas 12 mg/L • El hierro de la leche materna se absorbe 50% y el de la leche de vaca 10%

Prevención deficiencia de Fe • Sociedad Europea de Gastroenterología y Nutrición Pediátrica – Todo pre termino alimentado con leche humana o formulas debe recibir 2 - 2. 5 mg/kg/día de hierro elemental iniciando no después de las 8 semanas y continuar hasta los 12 -15 meses de vida.

Prevención • Se recomienda en los niños investigar niveles de Hb entre el 9 -12 m, 6 meses mas tarde y luego anualmente desde los 2 -5 años. • Antes de los 6 meses (a los 2 m) en niños pre término o de bajo peso al nacer y alimentados exclusivamente con leche materna

Estadios de la deplecion de Fe 1. Depleción de hierro: Reservas tisulares disminuidas con cambios en los niveles séricos de hierro. Ferritina sérica disminuida 2. Eritropoyesis deficiente en hierro: Ocurre cuando las reservas de hierro en los macrófagos están completamente agotadas. Cae el Fe sérico, aumenta capacidad total combinación. Eritropoyesis reducida y aumenta receptor transferrina sérica, saturac TF baja 3. Anemia deficiencia de Fe: micro e hipocromía, RDW y PPE elevada,

Prueba terapéutica con Fe • Reticulocitosis con pico 5 -10 días después de iniciar el tratamiento • Incremento en la cifra de Hb en promedio 0. 25 a 0. 4 g/dl/día o el Hto incrementa 1%/día, 1 gr/mes • Hierro elemental 4 -6 mgs/Kg/dia • La via oral es la via de eleccion

• El diagnostico diferencial de la anemia microcitica hipocromica incluye: a. b. c. d. e. Talasemia Anemia de la Enfermedad inflamatoria crónica Anemia deficiencia de hierro Anemia sideroblastica Todas las anteriores

• En relación a la anemia por deficiencia de hierro cual de las siguientes son correctas: a. La causa mas frecuente es la perdida crónica de sangre en orina b. El hierro sérico es el primer compartimento que se altera. c. El hierro se absorbe principalmente en duodeno y primera porción de yeyuno d. Los requerimientos de hierro están elevados en el tercer trimestre del embarazo e. Todas son falsas.

• En el diagnostico de la deficiencia de hierro, cuales de las siguientes afirmaciones son correctas? a. Hierro sérico bajo, capacidad total de transportación de hierro (TIBC) normal o baja y disminución del índice de saturación son hallazgos típicos de este cuadro b. La ferritina sérica refleja la cantidad de hierro almacenado en el organismo c. El estudio ferrocinético con Fe 59 muestra un rápido aclaramiento del hierro plasmático. d. La observación directa del hierro en las células de la médula ósea es el método mas preciso de evaluación del estado de los depósitos en el organismo. e. Todas son correctas

• Cual es el tratamiento de elección en la deficiencia de hierro? a. Administración de hierro oral en forma de sal férrica b. Hierro parenteral c. Hierro oral en la forma de sal ferrosa d. Solo modificar la dieta e. Tratar la causa desencadenante

• Cuales de las siguientes causas son mas probables para explicar la falta de respuesta al tratamiento? a. Intolerancia a los preparados de hierro b. Mala absorción de hierro c. Toma irregular de la medicación d. Coexistencia de otros procesos patológicos e. Todos los anteriores

Caso Clínico • Masculino 6 meses de edad, producto de gesta VI, embarazo gemelar, 34 SDG. Peso al nacer 1500 gr. Egresó del cunero 2 semanas despues, alimentado con leche materna hasta la actualidad. Aun no ablactado. • Acude por irritabilidad, fiebre, tos y rinorrea • EF: peso: 5 kg. Pálido, irritable, no control de cuello. Faringe hipermica, No visceromegalias. • BH: Hb 4. 5 gr, Hto 13. 9%, VCM 68 fl, CMHC 27, reticulocitos 0. 2%

• Ante este cuadro clínico, cual seria su diagnostico mas probable

Tratamiento a. Hierro oral 30 mgs hierro elemental al dia y vigilar respuesta b. Hierro oral 10 mgs hierro elemental al dia c. Hierro oral 10 mgs hierro elemental cada tercer dia d. consejo a la madre para aumentar hierro en la dieta

CASO CLINICO Femenino de 18 años, procedente de Ciudad Valles. Antecedente ictericia desde los 2 años de edad. A los 6 años le diagnosticaron anemia. Un hermano y su madre con ictericia conjuntival. Examen físico: Ictericia escleral +. No hepatomegalia. Esplenomegalia 3 cms. BH: Hb 10. 2 grs, GR 3. 6 x 106 /L, VGM 76 fl, HCM 28. 3 pg, CMHC 38%, retis 8%. Coombs directo negativo. QS, PFH normales. BI 2. 4 mg/dl. FSP formas esfericas, hipercrómicas de GR. Electroforesis de Hb, piruvatocinasa y G 6 PD normales. USG abdomen: Esplenomegalia, Litiasis vesicular. Resistencia globular osmótica disminuida.

• Ante los datos clínicos cual es el diagnostico mas probable? a. Anemia hemolitica autoinmune b. Deficiencia de Glucosa 6 fosfato deshidrogenasa c. Deficiencia de hierro d. Drepanocitosis e. Esferocitosis hereditaria (Enfermedad de Minkowsky Chauffard)

• Respecto a la fisiopatología, cual de las siguientes aseveraciones son correctas? a. El defecto proteico del esqueleto de la membrana eritrocitaria es déficit de espectrina b. Es una anemia hemolítica secundaria a una enzimopatía c. La mayoría de los casos se transmiten de modo autosómico recesivo d. La alteración estructural se asocia a un aumento de la permeabilidad pasiva de la membrana del GR al sodio e. Los microesferocitos al ser menos deformables son retenidos por el filtro esplénico y fagocitados por macrófagos del sistema mononuclear fagocítico

• Que complicaciones cabria esperar en estos pacientes? a. Crisis de eritroblastopenia aguda b. Colelitiasis c. Litiasis renal d. Sintomatología hemorrágica e. Ulceras en piernas